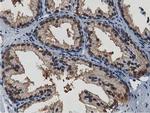
TACC3 Antibody in Immunohistochemistry (Paraffin) (IHC (P))

Search
OriGene
TACC3 Monoclonal Antibody (OTI3B1), TrueMAB™
{{$productOrderCtrl.translations['antibody.pdp.commerceCard.promotion.promotions']}}
{{$productOrderCtrl.translations['antibody.pdp.commerceCard.promotion.viewpromo']}}
{{$productOrderCtrl.translations['antibody.pdp.commerceCard.promotion.promocode']}}: {{promo.promoCode}} {{promo.promoTitle}} {{promo.promoDescription}}. {{$productOrderCtrl.translations['antibody.pdp.commerceCard.promotion.learnmore']}}
产品信息
CF501254
种属反应
宿主/亚型
分类
类型
克隆号
抗原
偶联物
形式
浓度
纯化类型
保存液
内含物
保存条件
运输条件
产品详细信息
For reconstitution, we recommend adding 100 µL distilled water to a final antibody concentration of about 1 mg/mL. To use this carrier-free antibody for conjugation experiments, we strongly recommend performing another round of desalting. (Zeba Spin Desalting Columns, 7KMWCO, 0.5 mL, Product # 89882)
靶标信息
TACC1 is located on 8p11 chromosomal region that is amplified in approximately 15% of all breast tumor samples. The short arm of chromosome 8 also contains FGFR1 whose expression is enhanced in most breast cancer tumors. TACC family members, TACC1, TACC2, and TACC3, map very closely to the corresponding FGFR1, FGFR2, FGFR3 genes on chromosomes 4,8, and 10. Subsequently, since they are phylogenetically related, it is proposed that TACC and FGFR have similar roles in cell growth and differentiation. Also, TACC1 contains a conserved C-terminal region as in the Drosophila homolog, D-TACC. It has been shown that D-TACC is necessary for normal spindle function, and the mammalian TACC proteins appears to interact with centrosomes and microtubules in a similar manner.
仅用于科研。不用于诊断过程。未经明确授权不得转售。
篇参考文献 (0)
生物信息学
蛋白别名: ERIC-1; Transforming acidic coiled-coil-containing protein 3; transforming, acidic coiled-coil containing protein 3
基因别名: ERIC-1; ERIC1; TACC3
UniProt ID: (Human) Q9Y6A5
Entrez Gene ID: (Human) 10460